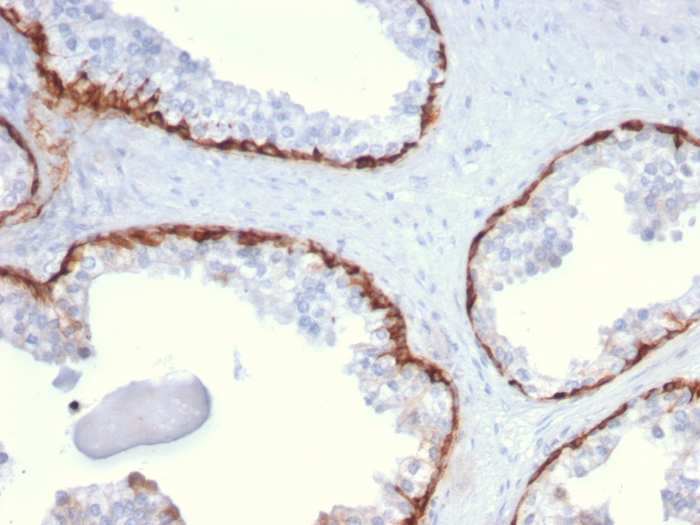

Formalin-fixed, paraffin-embedded human Prostate Carcinoma stained with Cytokeratin 15 Mouse Monoclonal Antibody (KRT15/2959)

Formalin-fixed, paraffin-embedded human Prostate Carcinoma stained with Cytokeratin 15 Mouse Monoclonal Antibody (KRT15/2959).

Confocal immunofluorescence image of MCF-7 cells using Cytokeratin 15 Mouse Monoclonal Antibody (KRT15/2959) followed by Goat anti-Mouse CF488 (Cyan) and Reddot is used to label the nuclei Red.

Western Blot Analysis of Human Thymus tissue lysate using Cytokeratin 15 Mouse Monoclonal Antibody (KRT15/2959)

SDS-PAGE Analysis Purified Cytokeratin 15 Mouse Monoclonal Antibody (KRT15/2959). Confirmation of Purity and Integrity of Antibody

Analysis of Protein Array containing more than 19,000 full-length human proteins using Cytokeratin 15 Mouse Monoclonal Antibody (KRT15/2959). Z- and S- Score: The Z-score represents the strength of a signal that a monoclonal antibody (MAb) (in combination with a fluorescently-tagged anti-IgG secondary antibody) produces when binding to a particular protein on the HuProtTM array. Z-scores are described in units of standard deviations (SD's) above the mean value of all signals generated on that array. If targets on HuProtTM are arranged in descending order of the Z-score, the S-score is the difference (also in units of SD's) between the Z-score. S-score therefore represents the relative target specificity of a MAb to its intended target. A MAb is considered to specific to its intended target, if the MAb has an S-score of at least 2.5. For example, if a MAb binds to protein X with a Z-score of 43 and to protein Y with a Z-score of 14, then the S-score for the binding of that MAb to protein X is equal to 29.
Keratin 15 is a type I keratin which is expressed only in basal keratinocytes in stratified epithelia and does not appear to have a natural type II expression partner. Keratin 15 is down regulated in activated keratinocytes. Cytokeratin 15 is a specific marker of stem cells of the hair-follicle bulge and may be a useful marker for diagnosis between basal cell carcinoma (BCC) and trichoepithelioma. Trichoblastoma are benign neoplasms of follicular differentiation frequently found in nevus sebaceous. Many morphologic features are shared with nodular basal cell carcinoma, sometimes rendering a diagnosis difficult. Trichoblastoma and BCC show variable expression of Cytokeratin 15 and Cytokeratin 19, and absence of hair keratins.
There are no reviews yet.